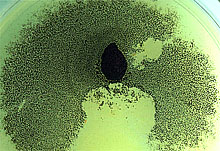

Aruna Kilaru
University of Louisiana-Lafayette
The four images I presented at the meeting were fortuitous observations and interpretations of my research work. Two of the images are scanning electron micrographs of the leaf surface of Theobroma cacao (the chocolate tree). The structures seen in the image "Spider Walk" are trichomes and the structures in "Thinker" are stomata. The other two photographs I presented are digital images and were the result of contamination during my attempt to grow the pathogen I work with, Crinipellis perniciosa (white colony on the image "Line of Control").
I earned my bachelor’s degree in Biology and Chemistry from Andhra University and master’s degree in biotechnology from MS University, in India. Currently, as a doctoral student, I am studying host-pathogen interaction in witches’ broom disease of cacao. I am quite intrigued and fascinated as to how plants communicate. I intend to study recognition and response mechanisms in plants as a postdoctoral fellow and subsequently as a faculty. Besides research I enjoy teaching and reading books and spending time with my daughter Rachana.
 click image |
|
 click image |
 click image |
|
click image |
Home Jane Davey Lindsey du Toit Brooke Edmunds
Sara Gremillion and Emily Cantonwine Adriana Murillo-Williams